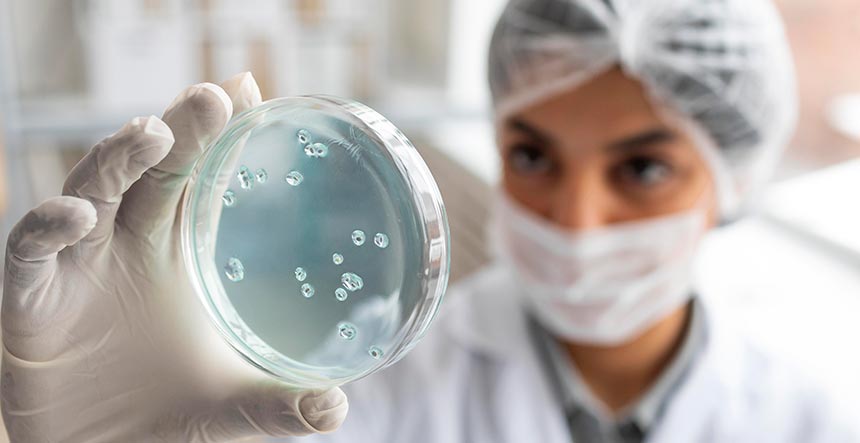
Diplomado en epidemiología

Abre la puerta a tu formación en epidemiología
Explorar un diplomado en epidemiología es una oportunidad única para fortalecer competencias en salud pública y análisis de datos, especialmente en un contexto donde la prevención y el control de enfermedades son fundamentales. Esta formación permite comprender cómo se originan, se propagan y se controlan las enfermedades en poblaciones, habilidades esenciales tanto para profesionales de la salud como para quienes buscan incursionar en investigación o gestión sanitaria. El Politécnico de Suramérica ofrece esta alternativa de manera 100% virtual, lo que significa que puedes acceder a la formación desde cualquier lugar de Colombia sin afectar tus responsabilidades laborales o personales.
Gracias a la modalidad de cursos online, los estudiantes tienen la flexibilidad de organizar su tiempo y avanzar a su propio ritmo, combinando teoría con prácticas aplicadas en casos reales del ámbito sanitario colombiano. Además, el diplomado no solo brinda conocimientos técnicos, sino que también fortalece habilidades en análisis de datos, interpretación de indicadores de salud y comunicación de resultados epidemiológicos de manera clara y efectiva.
Participar en este diplomado en epidemiología también abre la puerta a nuevas oportunidades profesionales, ya que permite desempeñarse en instituciones de salud pública, laboratorios de investigación, organizaciones internacionales y programas de prevención de enfermedades. A través de una metodología interactiva y acompañamiento constante, el Politécnico de Suramérica asegura que cada estudiante pueda consolidar su aprendizaje y aplicarlo de inmediato en entornos profesionales.
Si buscas actualizar tus competencias, ampliar tu perfil académico y contar con una certificación reconocida, este diplomado es la opción ideal. Con consejos prácticos, recursos virtuales y ejercicios aplicados, aprender epidemiología nunca fue tan accesible. Descubre cómo la educación virtual puede transformar tu carrera y cómo los cursos online del Politécnico de Suramérica te acompañan paso a paso hacia el logro de tus objetivos profesionales.
Tiempo de lectura estimado: 0 minutos
Índice
- Qué es un diplomado en epidemiología y para quién está diseñado
- Contenidos y competencias que adquirirás
- Metodología de estudio y modalidad virtual
- Ventajas de cursar este diplomado en Colombia
- Salidas profesionales y aplicabilidad de la formación
- Recomendaciones para aprovechar al máximo el diplomado
- Inscripción y próximos pasos con el Politécnico de Suramérica
- Impulsa tu carrera con un diplomado en epidemiología
Qué es un diplomado en epidemiología y para quién está diseñado

Un diplomado en epidemiología es un programa académico orientado a formar profesionales capaces de analizar, interpretar y aplicar información sobre la distribución y determinantes de enfermedades en poblaciones. Su objetivo principal es fortalecer competencias en salud pública, investigación aplicada y prevención de riesgos sanitarios. Este tipo de formación resulta clave para quienes desean contribuir de manera efectiva en la gestión de crisis sanitarias, programas de vacunación, estudios de brotes epidémicos o investigaciones sobre factores de riesgo en comunidades locales.
Este diplomado está diseñado para una amplia variedad de perfiles profesionales. Principalmente, se enfoca en profesionales de la salud, como médicos, enfermeros, biólogos y trabajadores de la salud pública, pero también es adecuado para estadísticos, sociólogos, administradores de programas sanitarios y otros profesionales interesados en adquirir habilidades para la interpretación de datos epidemiológicos.
La modalidad virtual del Politécnico de Suramérica, a través de cursos online, facilita el acceso a este conocimiento sin importar la ubicación geográfica. Esto permite que estudiantes de Medellín, Bogotá, Cali o municipios más alejados puedan participar activamente, combinando su formación con responsabilidades laborales o personales. Además, los cursos online ofrecen flexibilidad horaria y recursos interactivos, lo que optimiza la experiencia de aprendizaje y garantiza que los contenidos se comprendan y apliquen correctamente.
Consejos prácticos:
- Identifica tus objetivos profesionales antes de iniciar: ¿quieres enfocarte en investigación, gestión de programas o intervención comunitaria?
- Evalúa tu nivel en estadística y manejo de software; algunas habilidades básicas facilitarán tu avance en el diplomado.
- Aprovecha los foros y actividades prácticas que ofrece el Politécnico de Suramérica para generar networking y resolver dudas en tiempo real.
En resumen, un diplomado en epidemiología es accesible, flexible y útil para fortalecer tu perfil profesional, adaptándose a distintas necesidades y ofreciendo oportunidades de crecimiento dentro del sector salud en Colombia.
Contenidos y competencias que adquirirás
Al cursar un diplomado en epidemiología, los estudiantes adquieren conocimientos sólidos en salud pública y herramientas prácticas para analizar y gestionar información sanitaria. El programa se estructura en módulos diseñados para combinar teoría con aplicación directa, permitiendo que los participantes comprendan cómo se originan, se propagan y se controlan las enfermedades en distintas poblaciones. Gracias a la modalidad de cursos online ofrecida por el Politécnico de Suramérica, los contenidos se presentan de manera flexible, permitiendo que cada estudiante avance a su propio ritmo y aplique lo aprendido en contextos reales.
Entre los módulos más destacados del diplomado se incluyen:
- Bioestadística aplicada a la salud: interpretación de datos y creación de indicadores epidemiológicos.
- Vigilancia epidemiológica y control de brotes: seguimiento de casos y estrategias de prevención.
- Investigación epidemiológica: diseño y ejecución de estudios observacionales y experimentales.
- Análisis de datos en salud pública: uso de software estadístico y herramientas digitales para el análisis de información.
- Gestión de programas de prevención: planificación, ejecución y evaluación de iniciativas de salud comunitaria.
Las competencias que se desarrollan permiten:
- Analizar y sintetizar información epidemiológica.
- Interpretar indicadores de salud y comunicar resultados a distintos públicos.
- Aplicar metodologías de investigación para la prevención de enfermedades.
- Tomar decisiones fundamentadas en evidencia científica.
Ejemplos locales de aplicación:
- Implementación de programas de vacunación en Antioquia o Bogotá.
- Monitoreo de brotes de dengue, zika o influenza en municipios estratégicos.
- Elaboración de informes de salud pública para secretarías locales de salud.
Tips prácticos:
- Mantén actualizados tus conocimientos en software estadístico como SPSS, Excel o R.
- Participa activamente en simulaciones de casos reales que ofrece el Politécnico de Suramérica en sus cursos online.
- Aprovecha los foros de discusión para intercambiar experiencias con otros profesionales y enriquecer el aprendizaje.
En resumen, este bloque demuestra cómo un diplomado en epidemiología no solo aporta teoría, sino que capacita para la práctica profesional, fortaleciendo el perfil laboral y la capacidad de intervención en el sector salud colombiano.
Metodología de estudio y modalidad virtual
El diplomado en epidemiología del Politécnico de Suramérica se imparte completamente en modalidad virtual, ofreciendo a los estudiantes la flexibilidad de acceder a contenidos desde cualquier lugar de Colombia. Esta modalidad combina cursos online, actividades prácticas y tutorías personalizadas, garantizando que los participantes puedan avanzar a su propio ritmo sin comprometer la calidad de la formación. La metodología está diseñada para que la teoría se complemente con ejercicios aplicados, análisis de casos reales y resolución de problemas epidemiológicos locales.
Los estudiantes interactúan con recursos digitales como presentaciones interactivas, videos explicativos y simulaciones de brotes epidemiológicos. Además, las plataformas virtuales permiten la creación de foros de discusión y sesiones en vivo, donde los instructores del Politécnico de Suramérica acompañan a los participantes, responden dudas y brindan retroalimentación inmediata. Este enfoque promueve la participación activa y facilita la comprensión de conceptos complejos, desde bioestadística aplicada hasta gestión de programas de prevención.
Ventajas de la metodología virtual:
- Flexibilidad horaria: puedes organizar tu tiempo según tus responsabilidades laborales o personales.
- Accesibilidad: no importa si estudias desde Medellín, Bogotá, Cali o municipios más alejados; los cursos online te permiten avanzar sin desplazamientos.
- Aprendizaje práctico: resolución de casos reales y ejercicios de análisis de datos epidemiológicos aplicados a Colombia.
- Networking profesional: interacción con otros estudiantes y profesionales del sector salud.
Tips prácticos para aprovechar la modalidad virtual:
- Establece un horario semanal fijo para estudiar y realizar actividades.
- Mantén actualizadas tus herramientas digitales, como Excel, R o SPSS, que se utilizan en los ejercicios prácticos.
- Participa activamente en los foros y sesiones virtuales para enriquecer tu aprendizaje y crear conexiones profesionales.
- Realiza autoevaluaciones periódicas para medir tu comprensión de los módulos.
Ventajas de cursar este diplomado en Colombia
Cursar un diplomado en epidemiología ofrece múltiples beneficios para profesionales y estudiantes interesados en fortalecer su perfil en salud pública. Gracias a la modalidad de cursos online del Politécnico de Suramérica, los participantes pueden acceder a la formación sin importar su ubicación geográfica, desde Medellín hasta municipios más alejados, lo que elimina barreras de desplazamiento y optimiza el tiempo. Además, la flexibilidad horaria permite compaginar el estudio con responsabilidades laborales, personales o académicas, haciendo que la educación sea realmente accesible.
Otro aspecto importante es la calidad académica y la aplicabilidad práctica del contenido. El diplomado proporciona herramientas y conocimientos que pueden aplicarse de inmediato en la gestión de programas de prevención, análisis de brotes epidemiológicos y elaboración de informes de salud pública. Esta combinación de teoría y práctica fortalece la empleabilidad y abre oportunidades laborales en hospitales, laboratorios, secretarías de salud y organizaciones internacionales.
Comparativa de modalidades educativas: presenciales vs virtuales
| Característica | Presencial | Virtual (Politécnico de Suramérica) |
| Flexibilidad horaria | Baja | Alta, adaptada a tu ritmo |
| Ubicación | Limitada a la ciudad | Accesible desde cualquier lugar |
| Interacción con instructores | Directa | Virtual, con tutorías y foros |
| Aplicación práctica | Limitada a clases y laboratorios | Casos reales y simulaciones interactivas |
| Costos | Mayor | Más accesible, sin gastos de desplazamiento |
Tips prácticos para sacar el máximo provecho:
- Organiza tu agenda semanal, asignando tiempo específico para el estudio de cada módulo.
- Participa activamente en simulaciones y ejercicios de análisis de datos epidemiológicos.
- Aprovecha la interacción con instructores y compañeros para resolver dudas y compartir experiencias locales.
- Mantente actualizado en software estadístico y herramientas digitales que se usan durante el diplomado en epidemiología.
En conclusión, cursar este diplomado en Colombia combina calidad académica, flexibilidad y aplicabilidad profesional, consolidando competencias clave en epidemiología y salud pública, y facilitando que los estudiantes obtengan una certificación reconocida sin sacrificar tiempo ni recursos.
Salidas profesionales y aplicabilidad de la formación
Un diplomado en epidemiología no solo fortalece el conocimiento técnico en salud pública, sino que también abre un abanico de oportunidades profesionales en Colombia y en el ámbito internacional. Los egresados adquieren competencias para analizar información sanitaria, diseñar estrategias de prevención y tomar decisiones basadas en evidencia, habilidades altamente valoradas por empleadores del sector salud, investigación y organismos gubernamentales.
Entre las principales salidas profesionales se incluyen:
- Instituciones de salud pública: hospitales, clínicas y secretarías de salud en Medellín, Bogotá, Cali y otras regiones, donde se requiere personal capacitado en vigilancia epidemiológica y análisis de brotes.
- Laboratorios de investigación y control sanitario: análisis de datos de enfermedades, seguimiento de indicadores y contribución a estudios epidemiológicos.
- Organizaciones internacionales y ONG: participación en programas de prevención, estudios multicéntricos y proyectos de salud comunitaria.
- Gestión de programas de prevención y educación en salud: diseño e implementación de campañas de vacunación, promoción de hábitos saludables y control de enfermedades endémicas como dengue o influenza.
La modalidad de cursos online del Politécnico de Suramérica permite que los estudiantes puedan aplicar sus conocimientos de forma inmediata, desde análisis de datos hasta elaboración de informes y propuestas de intervención sanitaria, sin importar si están trabajando o estudiando en ciudades principales o zonas más alejadas.
Tips prácticos para potenciar la aplicabilidad profesional:
- Participa en proyectos locales o voluntariados estratégicos vinculados a la salud pública.
- Mantente actualizado en software estadístico y plataformas digitales utilizadas en investigación epidemiológica.
- Documenta tus prácticas y resultados para fortalecer tu portafolio profesional.
- Aplica los conceptos aprendidos en cursos online directamente a situaciones reales de tu entorno laboral o académico.
Recomendaciones para aprovechar al máximo el diplomado
Cursar un diplomado en epidemiología es una inversión de tiempo y esfuerzo que puede transformar tu perfil profesional en el sector salud. Para sacar el máximo provecho, es importante combinar disciplina, organización y participación activa en todas las actividades que ofrece el Politécnico de Suramérica, tanto en los cursos online como en los ejercicios prácticos y foros de discusión.
Consejos prácticos para optimizar el aprendizaje:
- Organiza tu tiempo de estudio: establece horarios semanales fijos y divide los módulos en bloques manejables para evitar sobrecarga.
- Aprovecha los recursos virtuales: videos, presentaciones interactivas y simulaciones epidemiológicas son herramientas que facilitan la comprensión de conceptos complejos.
- Participa activamente en foros y sesiones en vivo: compartir experiencias, dudas y soluciones con compañeros y tutores fortalece la comprensión y permite crear conexiones profesionales.
- Aplica los conceptos a situaciones reales: analiza casos locales de salud pública en Medellín, Bogotá o Antioquia y practica la elaboración de informes y estrategias de prevención.
- Mantente actualizado en herramientas digitales: programas como Excel, SPSS, R o Power BI son complementos esenciales para el análisis de datos en epidemiología.
- Realiza autoevaluaciones periódicas: medir tu progreso y reforzar conceptos donde notes debilidad ayuda a consolidar el aprendizaje.
- Crea un portafolio profesional: documenta proyectos, informes y análisis de datos realizados durante el diplomado para fortalecer tu perfil laboral.
La modalidad de cursos online permite aplicar estas recomendaciones sin restricciones de ubicación o tiempo, facilitando la combinación de estudios con responsabilidades laborales o personales. Además, los instructores del Politécnico de Suramérica brindan retroalimentación constante, lo que garantiza que los participantes puedan corregir errores, mejorar habilidades y comprender a fondo cada módulo.
Inscripción y próximos pasos con el Politécnico de Suramérica
Iniciar un diplomado en epidemiología es más sencillo de lo que imaginas gracias a la modalidad virtual ofrecida por el Politécnico de Suramérica. Este formato permite que cualquier persona en Colombia pueda acceder a la formación desde su hogar, oficina o incluso mientras se encuentra en tránsito, sin necesidad de desplazamientos prolongados. La inscripción se realiza de manera digital, garantizando un proceso rápido y seguro, y los cursos online brindan flexibilidad para organizar tu agenda según tus responsabilidades diarias.
Pasos para la inscripción:
- Ingresa al sitio web oficial del Politécnico de Suramérica y busca la sección del diplomado en epidemiología.
- Revisa los módulos, la duración del programa y los requisitos de admisión. Normalmente se solicita un título de educación media o superior dependiendo del perfil del participante.
- Completa el formulario de inscripción con tus datos personales y académicos.
- Confirma tu matrícula y selecciona la fecha de inicio que mejor se adapte a tu calendario.
- Accede a la plataforma virtual, descarga materiales y comienza tu experiencia educativa a través de los cursos online.
Recomendaciones para un inicio exitoso:
- Organiza un espacio de estudio tranquilo y con buena conexión a internet.
- Descarga y familiarízate con las herramientas digitales que se utilizarán durante el diplomado, como Excel, SPSS o R.
- Establece metas semanales para avanzar de manera constante en los módulos.
- Aprovecha los foros de interacción y tutorías en vivo para resolver dudas y compartir experiencias con otros profesionales.
Impulsa tu carrera con un diplomado en epidemiología
Cursar un diplomado en epidemiología representa una inversión estratégica para tu desarrollo profesional en el sector salud. Gracias a la modalidad de cursos online del Politécnico de Suramérica, es posible adquirir conocimientos especializados y competencias prácticas sin importar tu ubicación geográfica, combinando flexibilidad con calidad académica. Esta formación permite interpretar datos epidemiológicos, diseñar estrategias de prevención y aplicar soluciones basadas en evidencia científica, habilidades esenciales para hospitales, laboratorios, secretarías de salud y organizaciones internacionales.
Además, al completar el diplomado, los participantes fortalecen su perfil profesional y aumentan sus oportunidades laborales en Colombia. La combinación de teoría, práctica y ejercicios aplicados, sumada a la interacción con instructores y compañeros, asegura que cada estudiante pueda aplicar de inmediato los conocimientos adquiridos en entornos reales de salud pública. Participar en este programa no solo amplía competencias, sino que también contribuye al bienestar de la comunidad, aportando a la prevención y control de enfermedades en el país.
Si buscas actualizar tu formación, potenciar tu perfil profesional y acceder a una certificación reconocida, no hay mejor momento para inscribirte. Los cursos online del Politécnico de Suramérica te brindan la oportunidad de aprender de manera flexible, aplicada y con respaldo académico confiable. Aprovecha esta oferta educativa virtual y transforma tu carrera en salud pública a través de un diplomado en epidemiología que combina excelencia, practicidad y accesibilidad.


